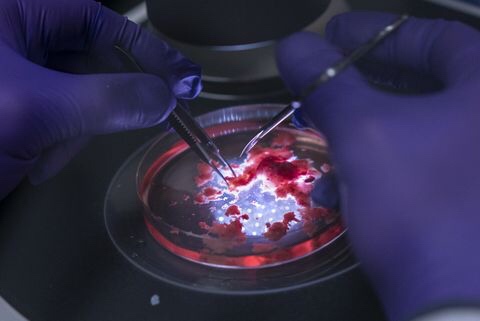

A second anonymously authored op-ed has been released on the website of Fox & Friends online, denying claims made in an op-ed released last week. We have obtained a copy of both the letter and Fox & Friends’ note accompanying the released version. Both follow. Late last week, the NY Times published an anonymously written... Continue Reading →
California aims to be entirely green powered by 2045, as Gov. Jerry Brown signs SB 100
Seeking to cement California's reputation as a global leader in combatting climate change, Gov. Jerry Brown on Monday signed two measures designed to push the state to 100 percent renewable electricity and so-called carbon neutrality by 2045. Senate Bill 100 raises the state’s already ambitious goals for producing electricity from wind, solar and other green... Continue Reading →
Georgia cancels registration of more than 591,500 voters
Georgia canceled the registration of more than a half-million voters over the weekend, part of an ongoing round of maintenance to clean up the state’s voting rolls. Each of the 591,548 voters affected by the move had already been on the state’s “inactive” registration list. That means they had not voted, updated their voter registration information,... Continue Reading →
Gov. Greg Abbott wants to change the Texas Constitution to ban the possibility of income tax
Texas doesn't have a personal income tax, and Gov. Greg Abbott wants to make sure it never will by adding the ban to the state constitution. Abbott announced the new policy proposal at a Republican rally held in McKinney on Monday. "Did you know that currently the Texas Constitution allows an income tax to be... Continue Reading →
California just voted to ban schools from starting before 8:30 a.m. so kids can sleep in
On August 31st, California lawmakers voted to ban middle schools and high schools from starting before 8:30 a.m. The goal? Getting students to sleep in. According to the Associated Press (AP), the bill, known as SB328, was narrowly passed by the state legislature ahead of a midnight deadline and is expected to be signed into... Continue Reading →
Activists occupying vacant house in Dublin take over third property this evening
HOUSING ACTIVISTS WHO have been occupying a vacant house on North Frederick Street in Dublin for the past few weeks have occupied another property in the city centre. Around 100 people gather on O’Connell Street this evening where they then marched to the property on Belvedere Court in the city. A group of activists had... Continue Reading →
Lab-grown brain bits open windows to the mind — and a maze of ethical dilemmas
Xuyu Qian yanked open an incubator door at the University of Pennsylvania to reveal rows of cylindrical tubes swirling, like shaken-up snow globes, with a strange and exotic flurry. The pale, peppercorn-sized spheres were lab-grown globules of human brain tissue, or, as Qian occasionally refers to them, “minibrains.” “Minibrain” is a controversial nickname, loathed by... Continue Reading →
The Imminent Impact of Artificial Intelligence and Bio-Engineering
There are two critical issues that will affect security over the next 20 years, artificial intelligence and bio-engineering (including nanotechnology). First, a few definitions: Artificial Intelligence (AI) AI is defined as an algorithm capable of being trained to identify live data and create activity based on that data. AI also has the capability to educate... Continue Reading →
Developers around the world are uniting for a cause that could save lives — here’s how IBM is helping
With wildfires once again raging through California, including the largest in the state's recorded history, it would be easy to lose faith in our ability to limit the damage caused by natural disasters. I reflected on this as teams gathered in Puerto Rico earlier this month, almost one year since Hurricane Maria tore through the... Continue Reading →
Everyone seems to agree Musk needs help running Tesla — Here’s who could do it
Tesla has reportedly been searching for years for a No. 2 to ease CEO Elon Musk's workload, even approaching Facebook Chief Operating Officer Sheryl Sandberg at one point. Executive recruiters and industry analysts agree Musk needs help. Musk's erratic behavior on Twitter has reportedly drawn a federal securities investigation and put Musk himself at risk... Continue Reading →